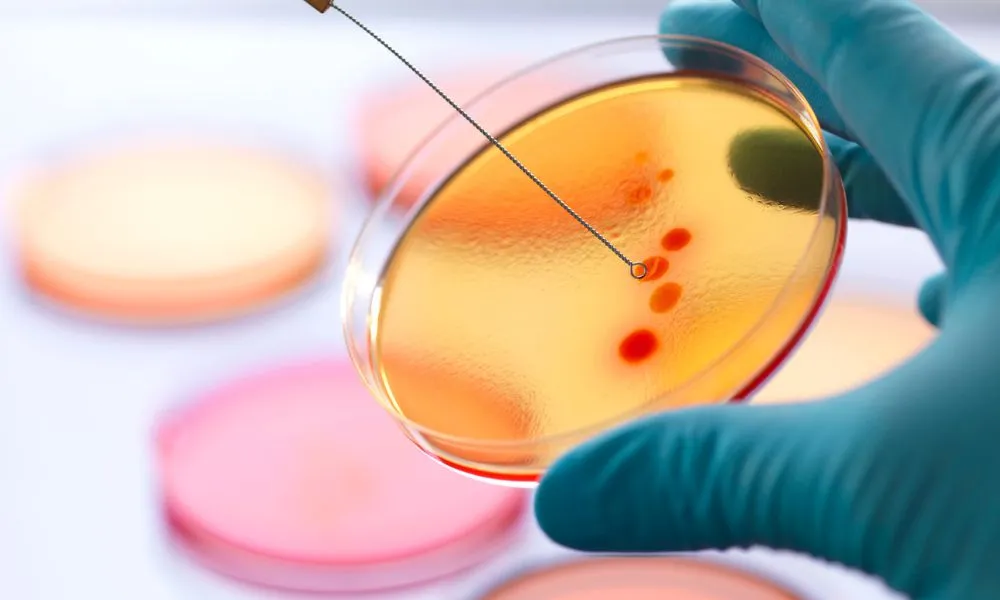
گرایش های رشته میکروبیولوژی

گرایش های رشته میکروبیولوژی

جهت مشاوره تلفنی در زمینه گرایش های رشته میکروبیولوژی
از تلفن ثابت در سراسر کشور با شماره ۱۶۱۳_۹۰۷_۹۰۹ (بدون پیش شماره) تماس بگیرید
پاسخگویی از ۸ صبح تا ۱۲ شب حتی ایام تعطیل
معرفی جامع گرایش های رشته میکروبیولوژی در مقاطع ارشد و دکتری. با تحلیل گرایشهای پزشکی، صنعتی، غذایی و محیطی، بهترین مسیر را برای آینده خود انتخاب کنید.
محتوایی که پیش روی شما قرار دارد، با هدف ترسیم یک نقشه راه علمی و شفاف برای یکی از حیاتی ترین علوم پایه، در واحد تولید محتوای تخصصی ذهن آگاهانه تدوین شده است.
مقدمه ای بر دنیای شگفت انگیز و متنوع میکروبیولوژی
میکروبیولوژی، علم مطالعه موجودات ذره بینی است. دنیایی نامرئی که بر تمام جنبه های زندگی ما، از سلامت و بیماری گرفته تا تولید غذا و حفظ محیط زیست، تاثیری شگرف دارد.
رشته میکروبیولوژی در مقطع کارشناسی، یک دید کلی از این دنیای پهناور ارائه میدهد. اما درخشش و موفقیت واقعی در این رشته، در گروی انتخاب هوشمندانه یکی از شاخه های تخصصی آن در مقاطع تحصیلات تکمیلی است.
گرایش های رشته میکروبیولوژی بسیار متنوع و گسترده هستند. هر یک از این گرایشها، پنجره ای نو به سوی یک حوزه تخصصی و یک بازار کار منحصربه فرد میگشاید.
در این مقاله جامع، ما به عنوان متخصصان ذهن آگاهانه، قصد داریم شما را با تمام این گرایشها آشنا کنیم. تا با ذهنی آگاه، بهترین و مناسب ترین شاخه را برای ادامه مسیر علمی و شغلی خود برگزینید.
برای هر گونه مشاوره از تلفن ثابت در سراسر کشور با شماره 9099071613 (بدون پیش شماره) تماس بگیرید. پاسخگویی از ۸ صبح تا ۱۲ شب حتی ایام تعطیل.
گرایش های رشته میکروبیولوژی
گرایش های رشته میکروبیولوژی را میتوان به چند دسته اصلی تقسیم کرد. این تقسیم بندی، بر اساس نوع میکروارگانیسم مورد مطالعه یا کاربرد آن در حوزه های مختلف صورت میگیرد.
انتخاب هر یک از این گرایشها در مقطع کارشناسی ارشد، مسیر آینده شما را تا حد زیادی مشخص میکند. زیرا دروس، مهارتهای اکتسابی و در نهایت، بازار کار هر یک، کاملا متفاوت است.
چهار گرایش اصلی این رشته که در دانشگاههای ایران ارائه میشوند عبارتند از: میکروبیولوژی پزشکی، میکروبیولوژی صنعتی، میکروبیولوژی غذایی و میکروبیولوژی محیطی.
در ادامه این مقاله، ما به صورت تفصیلی، هر یک از این گرایشهای جذاب را کالبدشکافی خواهیم کرد تا شما با دیدی باز و اطلاعاتی کامل، دست به انتخاب بزنید.
میکروبیولوژی پزشکی: در خط مقدم مبارزه با بیماریها
این گرایش، شناخته شده ترین و پرطرفدارترین در میان گرایش های رشته میکروبیولوژی است. تمرکز اصلی این حوزه، بر روی مطالعه میکروارگانیسم های بیماری زا (پاتوژن) برای انسان است.
یک میکروبیولوژیست پزشکی، به بررسی باکتریها، ویروسها، قارچها و انگلهایی میپردازد که مسبب انواع عفونتها هستند. او به دنبال شناخت راههای تشخیص، پیشگیری و درمان این بیماریهاست.
بازار کار اصلی این گرایش در بیمارستانها، آزمایشگاههای تشخیص طبی، مراکز تحقیقاتی و شرکتهای داروسازی است. این رشته، ارتباط تنگاتنگی با علوم پزشکی و داروسازی دارد.
تحصیل در این گرایش، نیازمند علاقه به حوزه های درمانی و پزشکی، دقت بالا در کار آزمایشگاهی و داشتن روحیه ای است که با درد و رنج بیماران سر و کار دارد.
برای مشاوره با شماره تلفن مجموعه خواجه نصیر شماره تلفن: 02148098 جهت کلاس خصوصی عمومی و تیزهوشان و نمونه دولتی و انتخاب رشته تماس بگیرید.
میکروبیولوژی صنعتی: استفاده از میکروبها برای تولید ثروت
این گرایش، پلی میان علم میکروبیولوژی و مهندسی است. در میکروبیولوژی صنعتی، از میکروارگانیسم ها به عنوان کارخانه های زنده و کوچک برای تولید محصولات ارزشمند استفاده میشود.
تولید انواع آنتی بیوتیکها، واکسنها، آنزیمهای صنعتی، اسیدهای آلی، سوختهای زیستی و ویتامینها، تنها بخشی از کاربردهای این شاخه از گرایش های رشته میکروبیولوژی است.
فارغ التحصیلان این گرایش میتوانند در کارخانه های داروسازی، صنایع تخمیری، شرکتهای تولید کننده مواد شیمیایی و موسسات پژوهشی مرتبط با بیوتکنولوژی مشغول به کار شوند.
این گرایش برای افرادی مناسب است که علاوه بر دانش بیولوژیک، به فرآیندهای تولید، مهندسی و کار در مقیاس صنعتی نیز علاقه مند هستند.
میکروبیولوژی غذایی: تضمین سلامت و کیفیت سفره های ما
این گرایش به بررسی نقش میکروارگانیسمها در مواد غذایی میپردازد. این نقش، میتواند هم مفید و هم مضر باشد که هر دو جنبه، در این گرایش مورد مطالعه قرار میگیرند.
از یک سو، میکروبیولوژیست غذایی به مطالعه میکروبهای مفید در فرآیندهای تخمیری مانند تولید ماست، پنیر، نان و سرکه میپردازد.
از سوی دیگر، او مسئولیت کنترل کیفیت و شناسایی میکروبهای بیماری زا و عامل فساد در مواد غذایی را بر عهده دارد تا از سلامت مصرف کنندگان محافظت کند.
بازار کار این گرایش در کارخانه های تولید مواد غذایی، سازمانهای نظارتی مانند سازمان غذا و دارو و آزمایشگاههای کنترل کیفیت است.
میکروبیولوژی محیطی: ناجیان کوچک سیاره زمین
این گرایش از گرایش های رشته میکروبیولوژی به مطالعه نقش حیاتی میکروارگانیسمها در اکوسیستم های طبیعی میپردازد. میکروبها، بازیگران اصلی چرخه های زیستی در آب، خاک و هوا هستند.
یک میکروبیولوژیست محیطی، از توانایی میکروبها برای تصفیه فاضلابها، پاکسازی آلودگیهای نفتی (زیست پالایی)، تولید کودهای زیستی و کنترل آفات استفاده میکند.
این گرایش، علمی سبز و در راستای حفظ محیط زیست و توسعه پایدار است. فارغ التحصیلان آن میتوانند در سازمان حفاظت محیط زیست، شرکتهای آب و فاضلاب و موسسات تحقیقاتی کشاورزی فعالیت کنند.
این رشته برای علاقه مندان به طبیعت، محیط زیست و کار در فضای میدانی و آزمایشگاهی به صورت توامان، بسیار جذاب خواهد بود.

جدول مقایسه ای جامع گرایش های رشته میکروبیولوژی
این جدول به شما کمک میکند تا با یک نگاه، تفاوتهای کلیدی میان چهار گرایش اصلی را درک کرده و آنها را با یکدیگر مقایسه نمایید.
| معیار | میکروبیولوژی پزشکی | میکروبیولوژی صنعتی | میکروبیولوژی غذایی | میکروبیولوژی محیطی |
| هدف اصلی | تشخیص و مبارزه با بیماریهای عفونی | تولید محصولات ارزشمند صنعتی و دارویی | کنترل کیفیت و ایمنی مواد غذایی | حفظ و پاکسازی محیط زیست |
| محیط کاری | بیمارستان، آزمایشگاه تشخیص طبی | کارخانه، شرکت داروسازی، مراکز رشد | کارخانه مواد غذایی، آزمایشگاه کنترل کیفی | سازمان محیط زیست، شرکتهای آب و فاضلاب |
| دروس کلیدی | باکتری شناسی، ویروس شناسی، ایمنی شناسی | بیوتکنولوژی، مهندسی ژنتیک، فرآیندهای تخمیر | میکروبیولوژی شیر و لبنیات، کنترل کیفی | اکولوژی میکروبی، زیست پالایی، میکروبیولوژی آب و خاک |
| روحیه مناسب | دقیق، مسئولیت پذیر، علاقه مند به پزشکی | خلاق، کارآفرین، علاقه مند به مهندسی | منظم، دقیق، حساس به سلامت عمومی | دغدغه مند محیط زیست، علاقه مند به کار میدانی |
این مقایسه، یک گام مهم در فرآیند “خودشناسی آگاهانه” است که ما در مجموعه ذهن آگاهانه بر آن تاکید داریم.
انتخاب گرایش در مقطع ارشد: وزارت علوم یا وزارت بهداشت؟
یکی از نکات بسیار مهم برای داوطلبان گرایش های رشته میکروبیولوژی در مقطع ارشد، تفاوت میان آزمون و دانشگاههای تحت پوشش وزارت علوم و وزارت بهداشت است.
وزارت علوم: دانشگاههای دولتی سراسری، آزاد و پیام نور تحت پوشش این وزارتخانه هستند. گرایشهای صنعتی، غذایی و محیطی عمدتا در این دانشگاهها ارائه میشوند.
وزارت بهداشت: دانشگاههای علوم پزشکی کشور تحت پوشش این وزارتخانه هستند. گرایش میکروبیولوژی پزشکی و گرایشهای وابسته مانند ویروس شناسی و قارچ شناسی، به طور تخصصی در این دانشگاهها تدریس میشوند.
آزمون ورودی این دو وزارتخانه نیز کاملا مجزا از یکدیگر برگزار میشود. بنابراین، شما باید از ابتدا تصمیم بگیرید که قصد شرکت در کدام آزمون و ورود به کدام حوزه را دارید.
آیا شما از این تفاوت مهم اطلاع داشتید؟ نظرات و سوالات خود را در این زمینه با ما و دیگران به اشتراک بگذارید.
دانشگاه های برتر برای هر یک از گرایش های میکروبیولوژی
انتخاب دانشگاه معتبر، تاثیر بسزایی در آینده علمی و شغلی شما دارد. در ادامه به معرفی دانشگاههای برتر در هر گرایش میپردازیم.
دانشگاههای برتر در گرایشهای وزارت علوم (صنعتی، غذایی، محیطی)
- دانشگاه تهران (دانشکده علوم و دانشکده فنی): به عنوان جامع ترین و برترین دانشگاه کشور.
- دانشگاه شهید بهشتی
- دانشگاه تربیت مدرس
- دانشگاه الزهرا (ویژه خانمها)
- دانشگاه فردوسی مشهد
- دانشگاه اصفهان
دانشگاههای برتر در گرایشهای وزارت بهداشت (پزشکی و وابسته)
- دانشگاه علوم پزشکی تهران: قطب اصلی علوم پزشکی در کشور.
- دانشگاه علوم پزشکی شهید بهشتی
- دانشگاه علوم پزشکی ایران
- دانشگاه علوم پزشکی شیراز
- انستیتو پاستور ایران: به عنوان یک مرکز تحقیقاتی-آموزشی فوق تخصصی.
برای هر گونه مشاوره از تلفن ثابت در سراسر کشور با شماره 9099071613 (بدون پیش شماره) تماس بگیرید. پاسخگویی از ۸ صبح تا ۱۲ شب حتی ایام تعطیل.
تحلیل بازار کار هر گرایش: کدام آینده شغلی بهتری دارد؟
این سوال، پاسخ قطعی و مشخصی ندارد. آینده شغلی هر فرد، بیش از نام گرایش، به مهارت، دانش، خلاقیت و تلاش خود او بستگی دارد. با این حال، میتوان تحلیلی کلی ارائه داد.
میکروبیولوژی پزشکی: به دلیل ارتباط مستقیم با نظام سلامت، بازار کار نسبتا باثباتی دارد. اما رقابت برای کسب موقعیتهای شغلی خوب در آن بسیار شدید است.
میکروبیولوژی صنعتی و غذایی: این دو گرایش به شدت به وضعیت اقتصادی و صنعتی کشور وابسته هستند. در شرایط رونق اقتصادی، بازار کار آنها بسیار خوب و با پتانسیل درآمدی بالا است.
میکروبیولوژی محیطی: این گرایش در ایران نسبتا جدیدتر است و بازار کار آن در حال توسعه است. با افزایش اهمیت مسائل زیست محیطی در کشور، آینده روشنی برای این گرایش پیش بینی میشود.

جدول تصمیم: انتخاب بهترین گرایش بر اساس علاقه و توانمندی
این ماتریس به شما کمک میکند تا با ارزیابی علایق و توانمندیهای خود، بهترین و مناسب ترین گرایش را از میان گرایش های رشته میکروبیولوژی برای خود انتخاب کنید.
| سوال کلیدی از خودتان | اگر پاسخ “بله” است، این گرایشها مناسب شماست |
| آیا به کمک به بیماران و کار در محیطهای درمانی علاقه دارید؟ | میکروبیولوژی پزشکی، ویروس شناسی، قارچ شناسی |
| آیا از ایده پردازی برای تولید یک محصول جدید لذت میبرید؟ | میکروبیولوژی صنعتی، بیوتکنولوژی میکروبی |
| آیا به سلامت و ایمنی مواد غذایی اهمیت زیادی میدهید؟ | میکروبیولوژی غذایی |
| آیا دغدغه حفظ محیط زیست و کار برای سیاره زمین را دارید؟ | میکروبیولوژی محیطی، اکولوژی میکروبی |
| آیا به کار با کامپیوتر و تحلیل داده های ژنتیکی علاقه دارید؟ | بیوانفورماتیک، میکروبیولوژی سیستمیک |
روایت های واقعی از کار و تحصیل در گرایش های مختلف
این روایتها، تجربیات شیرین و تلخ دانشجویان و فارغ التحصیلان گرایش های رشته میکروبیولوژی است.
- آزاده، کارشناس ارشد میکروبیولوژی پزشکی (مثبت): “کار در آزمایشگاه بیمارستان بسیار حساس و پر استرس است. اما وقتی با تشخیص درست به درمان یک بیمار کمک میکنی، تمام خستگی ات از بین میرود.”
- بهرام، فعال در حوزه تولید پروبیوتیکها (مثبت): “من با مدرک میکروبیولوژی صنعتی، شرکت دانش بنیان خودم را راه اندازی کردم. مسیر سختی بود اما الان از کارآفرینی و تولید ثروت لذت میبرم.”
- شیوا، مسئول کنترل کیفیت کارخانه لبنی (راضی): “شغلم روتین اما بسیار مهم است. مسئولیت سلامت هزاران نفر بر عهده من است. درآمد و امنیت شغلی خوبی هم دارم.”
- داریوش، فارغ التحصیل میکروبیولوژی محیطی (چالش): “متاسفانه هنوز بازار کار این گرایش در ایران به خوبی جا نیفتاده است. پیدا کردن شغل مرتبط کمی سخت است اما من به آینده آن بسیار امیدوارم.”
- مریم، دانشجوی دکتری ویروس شناسی (پرتلاش): “دنیای ویروسها بی نهایت شگفت انگیز است. کار تحقیقاتی بسیار سخت و زمانبر است اما من عاشق کشف ناشناخته ها هستم.”
- نوید، انصراف داده از ارشد (دیدگاه): “من فهمیدم که روحیه کار آزمایشگاهی و صبر و حوصله زیاد را ندارم. تغییر مسیر دادم و وارد بازار کار فروش تجهیزات آزمایشگاهی شدم و موفق ترم.”
- سارا، شاغل در شرکت داروسازی (مثبت): “در بخش تحقیق و توسعه یک شرکت داروسازی کار میکنم. کار ما بر روی تولید آنتی بیوتیکهای جدید است. حس بسیار خوبی دارد.”
- رضا، دانشجوی دانشگاه آزاد (امیدوار): “درست است که در دانشگاه دولتی قبول نشدم، اما با تلاش زیاد و یادگیری مهارتهای نرم افزاری، خودم را برای یک بازار کار رقابتی آماده میکنم.”
- فرشته، کارشناس سازمان غذا و دارو (مهم): “ما به عنوان ناظر، مسئولیت سنگینی در تضمین سلامت محصولات غذایی داریم. کار ما، یک کار حاکمیتی و بسیار حساس است.”
- کاوه، مدرس دانشگاه (توصیه): “به دانشجویانم میگویم که از همان ابتدا، به فکر تقویت زبان انگلیسی و یادگیری تکنیکهای مقاله نویسی باشند. اینها ابزارهای اصلی یک میکروبیولوژیست موفق هستند.”
سوالات متداول گرایش های رشته میکروبیولوژی
آیا با مدرک کارشناسی میکروبیولوژی میتوان وارد بازار کار شد؟ بله، اما فرصتهای شغلی برای مقطع کارشناسی محدودتر و عمدتا در سطح تکنسین آزمایشگاه است. برای کسب موقعیتهای شغلی تخصصی و مدیریتی، ادامه تحصیل در مقطع ارشد ضروری است.
کدام گرایش میکروبیولوژی برای مهاجرت بهتر است؟ گرایشهای مرتبط با بیوتکنولوژی و میکروبیولوژی صنعتی، به دلیل ماهیت فناورانه و کاربردی، معمولا فرصتهای بهتری برای مهاجرت و کار در شرکتهای دانش بنیان خارجی فراهم میکنند.
آیا این رشته نیاز به کار با حیوانات آزمایشگاهی دارد؟ در برخی پروژه های تحقیقاتی، به ویژه در گرایش میکروبیولوژی پزشکی و در مراحل تولید واکسن و دارو، ممکن است از حیوانات آزمایشگاهی استفاده شود.
آیا این رشته برای خانمها مناسب است؟ بله، کاملا. این رشته هیچ محدودیت جنسیتی ندارد و به دلیل نیاز به دقت، صبر و ظرافت در کار آزمایشگاهی، بسیاری از موفق ترین میکروبیولوژیست های جهان، خانمها هستند.
برای موفقیت در این رشته، باید در کدام دروس دبیرستان قوی باشیم؟ درس زیست شناسی، مهمترین و اصلی ترین درس است. پس از آن، داشتن پایه قوی در دروس شیمی و زبان انگلیسی نیز برای موفقیت در این رشته بسیار ضروری است.
بازار کار این رشته در ایران اشباع شده است؟ در گرایشهای سنتی و در سطح کارشناسی، تا حدودی بله. اما در گرایشهای جدیدتر و در سطوح تخصصی (ارشد و دکتری)، همچنان نیاز زیادی به نیروی انسانی متخصص و ماهر وجود دارد.
آیا امکان کارآفرینی و تاسیس شرکت شخصی در این رشته وجود دارد؟ بله، به خصوص در گرایش میکروبیولوژی صنعتی و غذایی. تولید محصولات پروبیوتیک، کیتهای تشخیصی، کودهای زیستی و راه اندازی آزمایشگاههای همکار، از زمینه های خوب برای کارآفرینی هستند.
تفاوت اصلی میکروبیولوژی با بیوتکنولوژی چیست؟ میکروبیولوژی یک علم پایه است که به شناخت خود میکروارگانیسمها میپردازد. بیوتکنولوژی، یک علم کاربردی است که از ابزارهای مختلف (از جمله میکروبها) برای تولید یک محصول یا ارائه یک خدمت استفاده میکند. این دو حوزه، همپوشانی زیادی با هم دارند.
آیا دروس این رشته سخت و پر حجم هستند؟ بله، مانند تمام رشته های علوم پایه، میکروبیولوژی نیز نیازمند مطالعه مستمر و عمیق است. حجم مطالب و نامهای لاتین ممکن است در ابتدا کمی دشوار به نظر برسد.
برای ورود به مقطع ارشد، باید در کنکور کدام مجموعه امتحانی شرکت کنیم؟ برای گرایشهای وزارت علوم، باید در کنکور کارشناسی ارشد مجموعه زیست شناسی سلولی و مولکولی شرکت کنید. برای گرایشهای وزارت بهداشت، باید در کنکور مجموعه علوم آزمایشگاهی (یا مجموعه های مرتبط) شرکت نمایید.

نتیجه گیری: آینده در دستان متخصصان علوم زیستی است
در این مقاله بسیار جامع، ما به معرفی و کالبدشکافی گرایش های رشته میکروبیولوژی پرداختیم. دیدیم که این رشته، دنیایی به مراتب بزرگتر و متنوع تر از تصورات عمومی است.
انتخاب هر یک از این گرایشها، یک تصمیم سرنوشت ساز است که باید بر اساس شناخت عمیق از خود، علایق، توانمندیها و همچنین واقعیت های بازار کار صورت گیرد.
قرن بیست و یکم، قرن علوم زیستی و بیوتکنولوژی است. بدون شک، آینده جهان به دستان متخصصانی گره خورده است که بتوانند از قدرت میکروارگانیسمها برای حل بزرگترین چالشهای بشری، از درمان بیماریها تا تامین غذا و حفظ محیط زیست، استفاده کنند.
مجموعه ذهن آگاهانه امیدوار است که این راهنمای دقیق، توانسته باشد چراغی روشن در مسیر انتخاب شما باشد. آینده از آن شماست، به شرطی که آن را آگاهانه بسازید.
مجموعه ذهن آگاهانه، به عنوان بزرگترین وبسایت در حوزه آموزش و مشاوره، افتخar دارد که در مسیر پر از انتخاب زندگی تحصیلی و شغلی، در کنار شما باشد. ما قدردانیم که تا پایان این مقاله با ذهن آگاهانه همراه بودید.
ذهن آگاهانه صمیمانه از همراهی شما تا انتهای این مقاله جامع سپاسگزاری میکند. امیدواریم با انتخابی آگاهانه، نقشی موثر در پیشرفت علم و بهبود زندگی بشر ایفا کنید.
جهت مشاوره تلفنی در زمینه گرایش های رشته میکروبیولوژی
از تلفن ثابت در سراسر کشور با شماره ۱۶۱۳_۹۰۷_۹۰۹ (بدون پیش شماره) تماس بگیرید
پاسخگویی از ۸ صبح تا ۱۲ شب حتی ایام تعطیل








